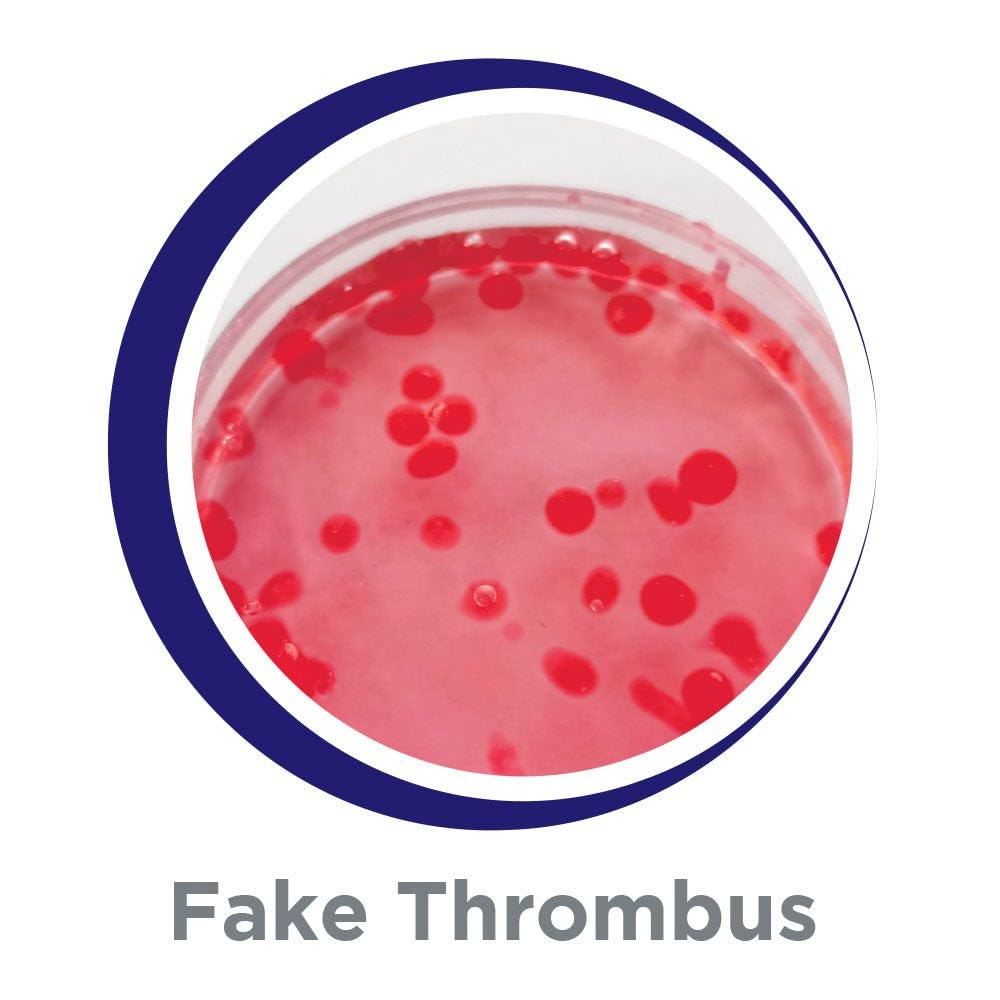
Mad Toys STEM Toy Disgusting and Gross 4 Revolting Science Experiment Kit with Easy to Follow Guidebook, Ideal Gift for Little Scientists Violet, Aged 8+ Years One size, 684585

"This DIY Mad Toys Disgusting and Gross Science Experiment Kit includes 4 horrifying but cool science experiments: ✔MAKING GREEN NOODLES Your kids will be amazed watching long green objects forming in the water, just like noodles or worm-like figures. ✔MAKING THROMBUS Create your own fake blood droplets with this easy to follow experiment and learn about the chemical reaction. ✔FEELING VOMIT Prepare a solution that feels like a squishy vomit inside two test tubes. ✔MAKING VOMIT Mixing the ingredients will make it hard but be surprise when you open your hand and released pressure, substance will turn into a liquid."
| ASIN | B0CB1YPRBN |
| Assembly Required | No |
| Batteries Required? | No |
| Best Sellers Rank | #203,186 in Toys ( See Top 100 in Toys ) #2,790 in Educational Science Kits |
| Color | Violet |
| Date First Available | 21 August 2023 |
| Educational Objective(s) | Exploratory Skills, Imagination Development, STEM |
| Item model number | 684585 |
| Manufacturer recommended age | 8 - 17 years |
| Material Type(s) | Cardboard, Plastic |
| Number of Game Players | 2 |
| Product Dimensions | 10 x 6 x 5 cm; 400 g |
| Release date | 18 August 2023 |
Trustpilot
2 weeks ago
3 weeks ago